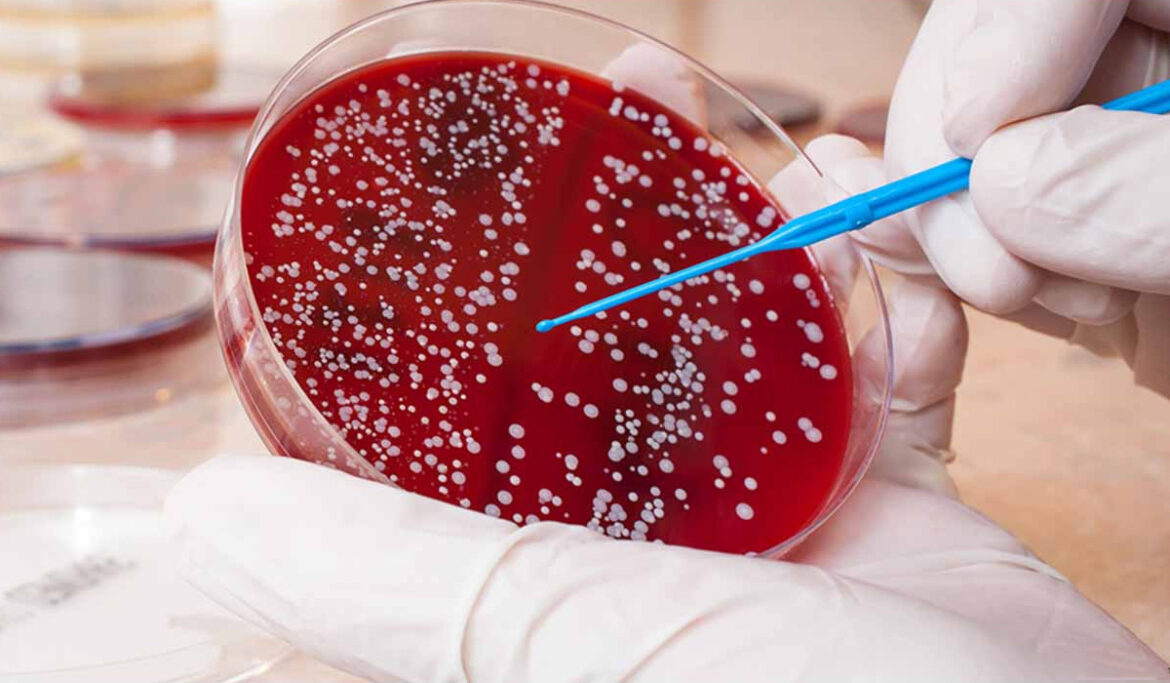
banner-blood-cancer

A Biopsy is a simple medical procedure, done in order to analyze a tissue, taken from the body, more closely. It is normally recommended by a physician if an initial test suggests some abnormality in a given tissue or region of the body.

The abnormal tissue concerned can either be called as a lesion, a tumor or a mass by a doctor. These names essentially indicate the anomalous nature of these tissues. Such a doubtful case may come up during a physical examination or test done on internal organs such an imaging test.
Why are Biopsies Performed?
In most cases, a biopsy is performed to check for any signs of cancer. But it can also help in bringing to light many other conditions and anomalies too.
Usually a doctor recommends a biopsy when she wants to further investigate a medical question which a biopsy could answer. A few instances can be given below:
- If a mole on the skin has recently changed shape, indicating the possibly of melanoma.
- A mammogram which demonstrates a mass or a lump which can suggest breast cancer.
- If a person is suffering from acute hepatitis and if a doctor wants to investigate the presence of cirrhosis.
In few cases, a biopsy of normal tissues could also be performed to check for the spread of cancer or to analyze if a transplanted organ has been rejected. In any case a biopsy helps to understand a problem more closely and to find its solution.
What are different types of Biopsies?
Biopsies are of many different kinds and almost all of them involves using a sharp instrument like a needle. If the procedure is to be performed on the skin or any sensitive area, the process will usually be associated with numbing the region with a medicine.
Some different types of biopsies can be mentioned below:
- Liver Biopsy: Here a needle is inserted into the liver through the belly skin to take out the sample of a liver tissue.
- Needle Biopsy: Since most biopsies need a sharp instrument to take a sample, needles are used in most cases to draw out or reach a doubtful tissue.
- Kidney Biopsy: The procedure is similar to Liver Biopsy where a needle is put from the back into the kidney to take out the sample.
- CT-guided Biopsy: This procedure involves a person resting inside a CT scanner, with scanner images guiding the doctors to the exact position of the needle to draw out the suspicious tissues.
- Ultrasound guided Biopsy: Similar to the CT guided procedure, here an ultrasound helps the doctor to locate the appropriate position of the needle in order to take the sample out.
- Bone Marrow Biopsy: Here a large needle is injected through the pelvis region to secure the bone marrow. This test helps to identify diseases such as lymphoma or leukemia.
- Bone Biopsy: As the name suggests, this biopsy is done to detect the cancer of bones. This can be done either by the CT scan procedure or by an orthopedic surgeon.
- Aspiration Biopsy: Aspiration Biopsy involves a needle drawing out sample material from a mass. This process has been named fine-needle aspiration in medical terms.
- Surgical Biopsy: This procedure is done in case the suspicious tissue is hard to access. This is done either by open or a laparoscopic method. Either the whole mass of the tissue may be removed or only a small part is taken to analyze the abnormality.
- Skin Biopsy: Punch Biopsy, a part of the skin biopsy is one of the main biopsy methods. This method uses a circular blade to take out a circular sample to detect any anomaly in the tissue.
- Prostrate Biopsy: This process need multiple biopsies at the same time from the prostate gland. To take out the sample, a probe is inserted through the rectum.
[Find Procedure for Prostrate Biopsy]
What can be expected from your biopsy?
The ease or difficulty accessing a suspicious tissue determine the type of biopsy. The term used in medicine for this is invasiveness. A biopsy involving a minimal procedure can be done in the doctor’s office only, where a small dose of numbing injection can make the process almost painless.
A biopsy involving advanced procedures or more invasion can be done in hospitals, a surgical center or a doctor’s office furnished with all the necessary equipment. The procedure may also involve administering sedatives or pain reliving medicines. For this you may have to take an appointment separately.
The area from where the biopsy sample is taken may feel sore for some days. Some pain reliving medicines can be taken on the prescription of doctor to subside the discomfort arising from biopsy procedure.
What happens post a biopsy?
After the sample has been collected, it is handed over to a pathologist. Pathologists are doctors who specialize in analyzing bodily samples to detect any abnormality in shape, size, texture or any other parameter. Usually one comes to know about the problem by measuring these parameters only. It usually take some time for results to come. During a surgery, a pathologist may have to report the result as soon as possible. In most cases, it may take a week or more to arrive at accurate results. Post this, one may have to follow up with their doctor to review up these results.
Get more details on Cancer Treatment in India at affordable cost.